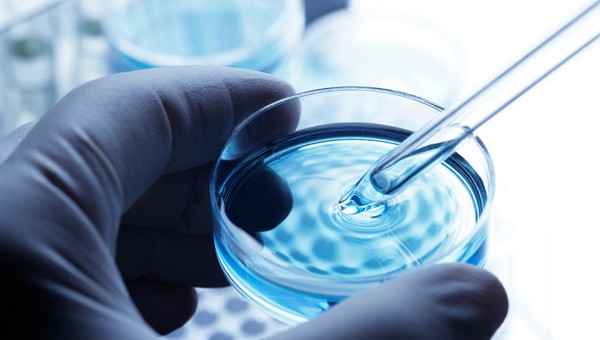
Drug Discovery

Discover the clinical and medical journals that we publish at Nature Research. These titles provide researchers, clinicians, trainees and allied health professionals with access to high-quality research from across the medical specialties. The journals help clinicians to support the advancement of the health and well-being of our global population.
Supporting every step from bench to bedside
Our journal content will keep you up-to-date with the latest developments and advances across the clinical and health sciences.
Nature Research journals
The research journals publish cutting-edge, original research, in addition to reviews, opinion and commentaries, which put new scientific breakthroughs into a wider context. The content is indispensable for researchers and students who want to stay up-to-date in their respective fields.
Nature Reviews journals
Nature Reviews journals publish high-quality, authoritative Reviews and Perspectives written by world-leading researchers. The clear and concise articles, with bespoke artwork, ensure that readers remain up-to-date with new advances throughout the clinical sciences.
How Review journals support the advancement of health and well-being

Annette Fenner
Chief Editor
Nature Reviews Urology
Tell us a little about your role and research background?
I’m the Chief Editor of Nature Reviews Urology, one of the 8 specialty clinical medicine journals in the Nature Reviews family. We cover all aspects of urology from basic research through translational medicine to clinical, patient-centred topics. My background is primarily medical - I trained as a clinician and completed my medical degree in 2010. However, during my medical degree I also intercalated a PhD in reproductive biology, both at Imperial College London. Thus, I have experience at both ends of the spectrum — basic science and patient-facing clinical medicine.
Our Reviews are an invaluable resource for anyone looking to get an in-depth update on a topic. For a busy reader, as well as providing everything you need to know on a subject in one place, they include clear and attractive figures that are an excellent resource for understanding and for using in talks and teaching. At Nature Reviews in particular, we ask authors to offer their own insights and to critique the data as well as describing the field. In that way, the reader knows that they are getting a thorough, timely, expert-led view of the topic.
Nature Reviews journals specialize in this article type, meaning that we invest a lot of time in each article to ensure that it is complete, comprehensive, and accessible. All our Reviews, Consensus Statements, and Perspectives are peer-reviewed and edited in house, with several rounds of revision, and collaboration between the authors and the editors. This means that readers know they can trust our content to be authoritative and relevant in their busy working lives.
Within the Nature Reviews family, we produce not only clinical specialty journals, but also a number of other journals that are really valuable to those working within a clinical environment. For those in drug discovery and R&D, our basic science Reviews — both in the clinical journals and in the Life Sciences Reviews journals such as Nature Reviews Cancer — introduce disease mechanisms and discuss potential drug targets, and, of course, Nature Reviews Drug Discovery is tailored for this field. These basic, mechanistic articles are also valuable for those working in clinical trials and clinical medicine professionals who are looking for a deeper understanding of disease pathology. Our more clinical articles are also a great resource for these groups, and are carefully put together to make them useful and accessible for all levels of medical professionals, from medical students looking for an overview of a disease (Nature Reviews Disease Primers is a great resource for these readers), up to senior consultants who want to remain up to date in their specialty by reading the relevant clinical Nature Reviews journal.